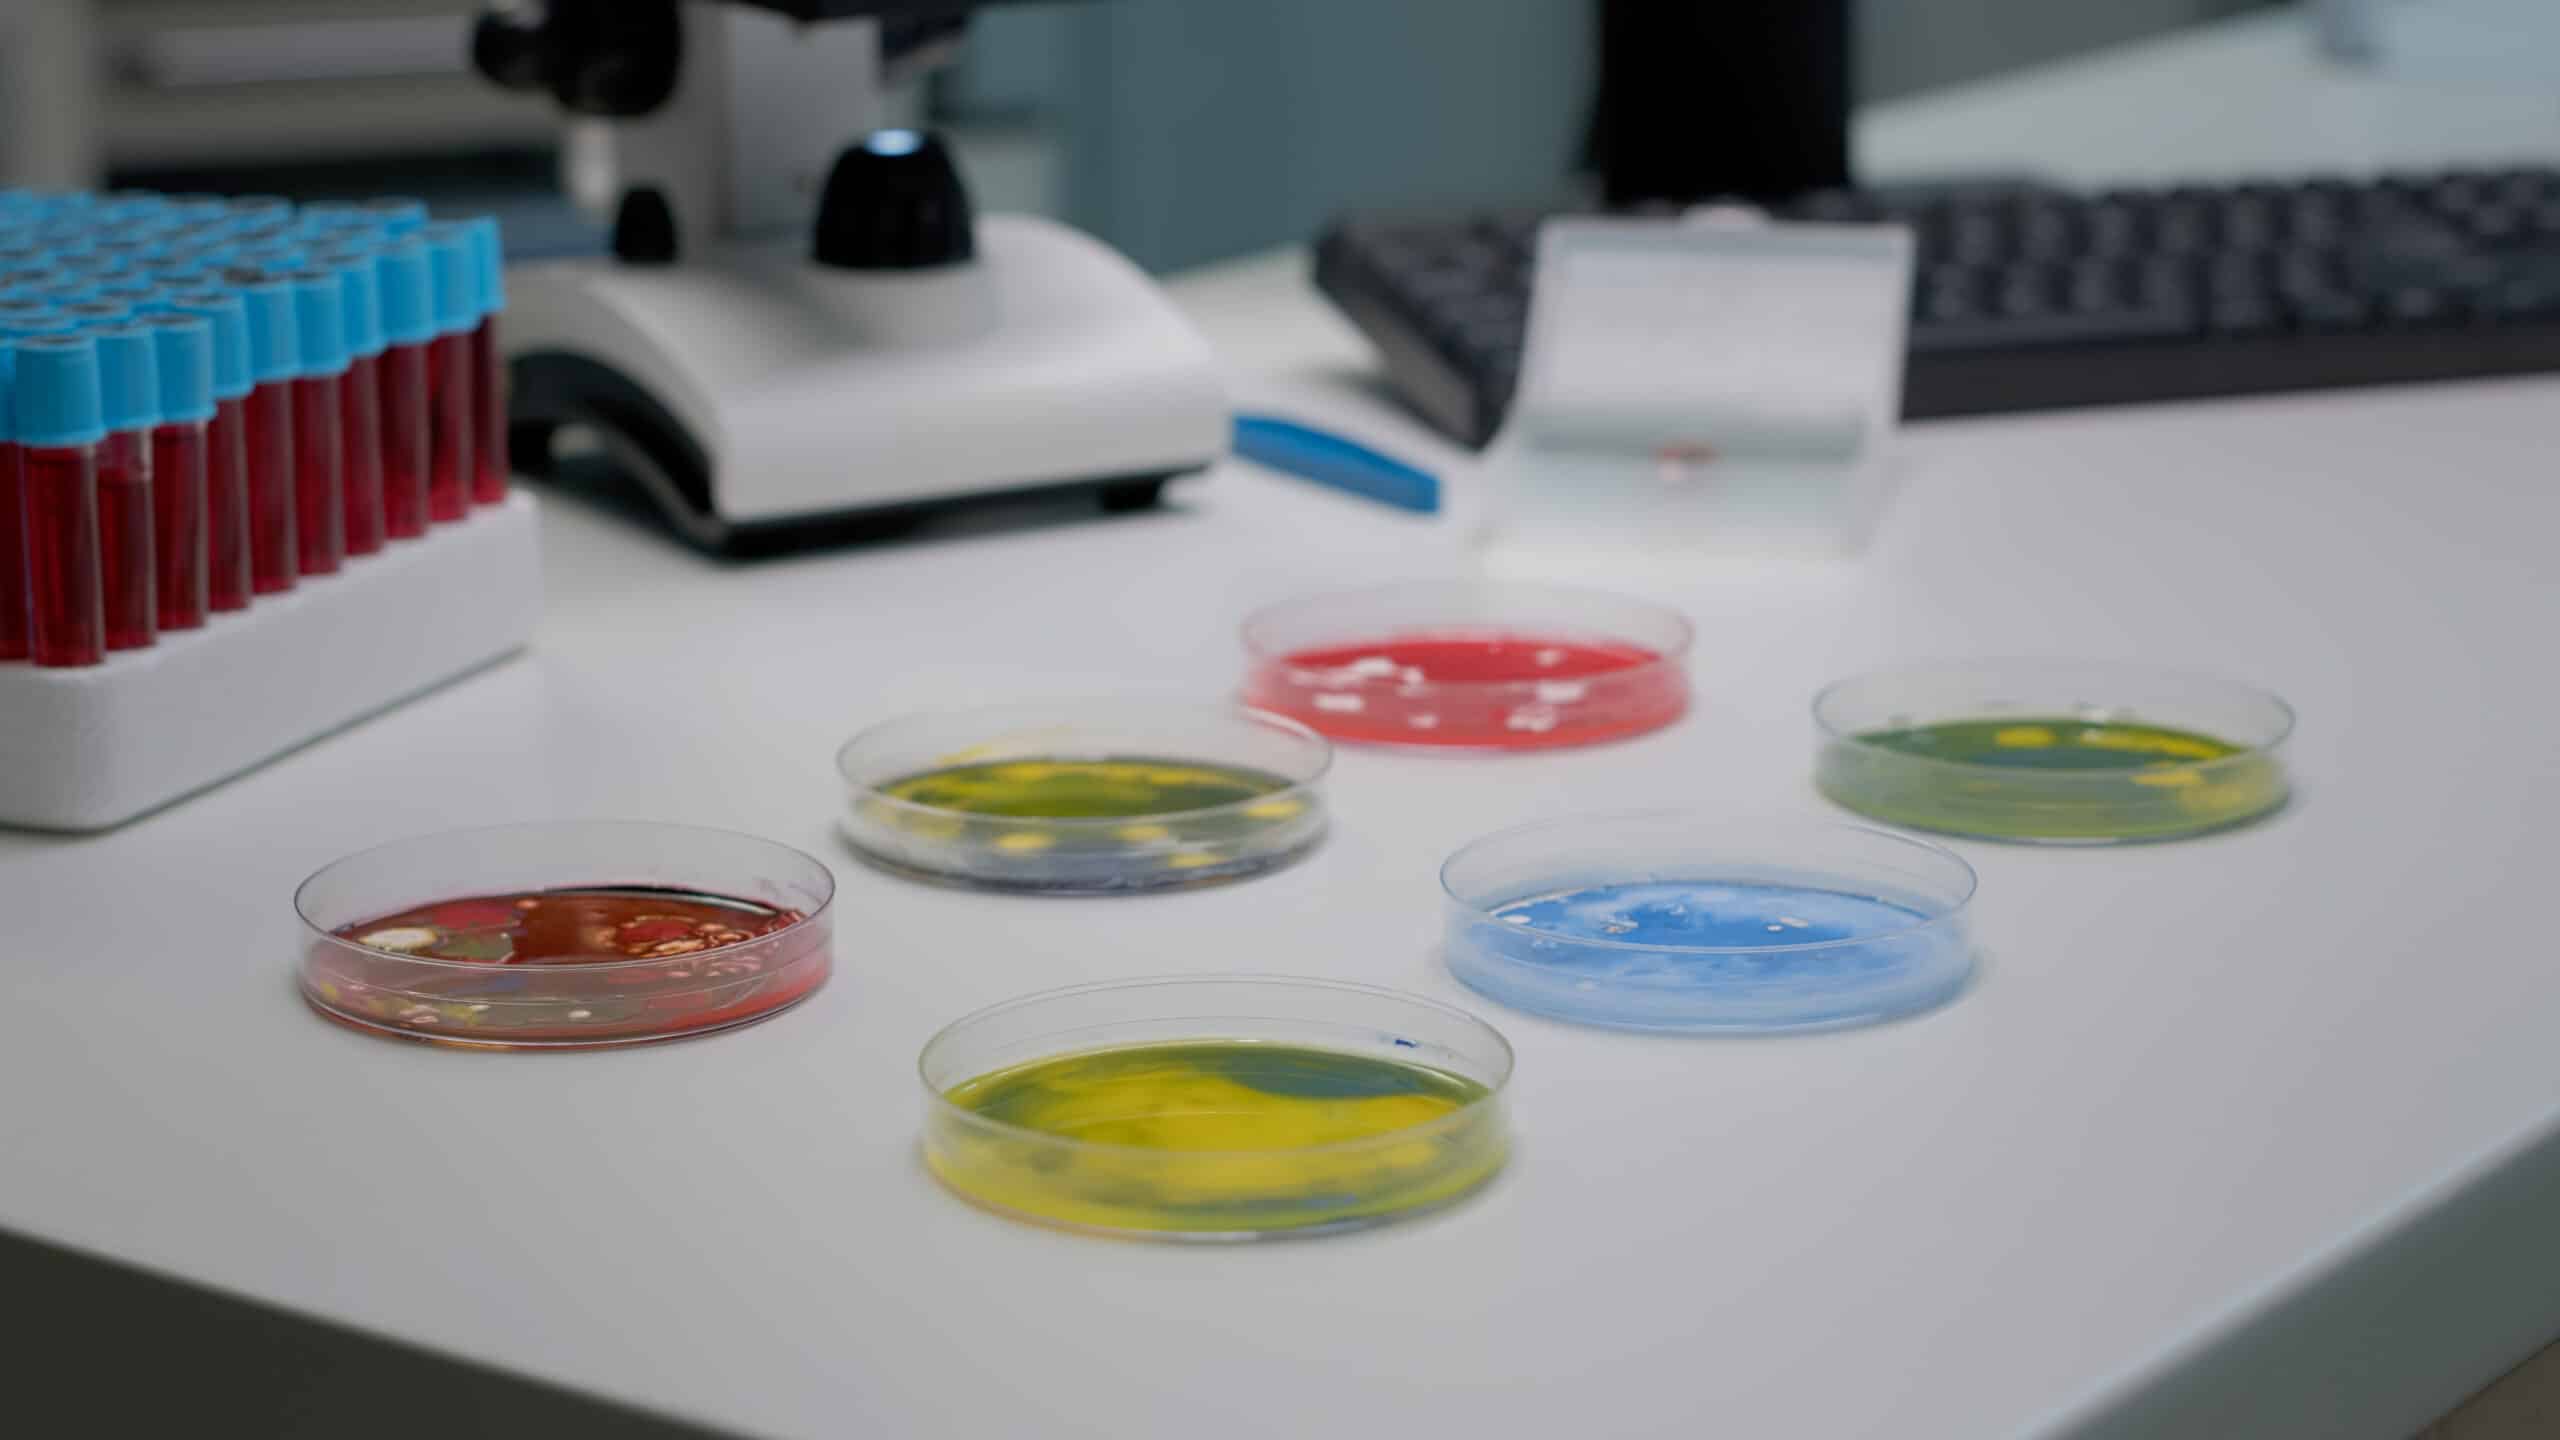

Sorts of Microbes in Microbiology
Whereas there are numerous, many several types of microbes that occupy the invisible areas round us, they sometimes fall right into a handful of classes: micro organism, viruses, fungi, protozoa, and algae.
Bacterial Microbes:
Micro organism are unicellular, or single-cell, organisms which can be independently reproducing. Whereas they’re very structurally easy, they operate in a really advanced manner. Micro organism type the idea for all life on Earth. A overwhelming majority of micro organism are helpful to their surroundings and play a wide range of essential roles of their ecosystem equivalent to recycling vitamins, breaking down poisonous compounds, and plenty of others.
Whereas a majority of micro organism are innocuous and even essential, there are additionally many bacterial infections that may trigger hurt to people and different residing beings.
GIDEON at present follows 129 bacterial illnesses, tracing their influence throughout the globe.
Viral Microbes:
Viruses are submicroscopic infectious brokers which can be solely capable of reproduce inside residing cells of different organisms. Viruses can infect all varieties of life kinds together with animals, people, and even different microbes equivalent to micro organism and archaea.
Viruses will be present in each single ecosystem on Earth and are believed to be probably the most quite a few sort of organic entities on our planet.
As a result of viruses reproduce in another way from different microorganisms, the therapy of viral infections requires a distinct strategy than bacterial infections.
GIDEON at present follows 110 viral illnesses day by day, in 235 nations and territories.
Fungal Microbes:
Fungi will be both single-celled or advanced multicellular organisms. They are often present in many alternative ecosystems and habitats however are sometimes discovered on land in soil or natural plant matter.
Some fungi are parasitic on crops and might trigger mildews, rusts, scabs, and cankers. Fungal infections could be a main difficulty for farmers and might result in main monetary losses.
A really small variety of fungi could cause illnesses in animals and people. For people, these illnesses most frequently afflict the pores and skin and trigger situations equivalent to ringworm, athletes’ foot, and thrush.
Whereas many fungal illnesses are thought-about minor, fungal invasions which were allowed to turn into multi-system infections will be detrimental and even take many years to get better from. For instance, many fungi that have an effect on the lungs are significantly harmful.
One fungus, Candida aura, is especially harmful because it thrives in people and might unfold in a short time. Additionally it is proof against all three main antifungal medicines making outbreaks a severe state of affairs.
GIDEON at present paperwork 26 fungal illnesses throughout the globe.
Protozoa:
Protozoa are single-celled organisms that are available a wide range of styles and sizes. Some protozoa, equivalent to paramecium, are a set and sophisticated form whereas others, equivalent to amoeba, are amorphous and might change their form.
Protozoa are cell microbes and might transfer utilizing tiny, hair-like cilia, lengthy tails known as flagella, and amoeboid motion the place the protozoa change form to propel themselves ahead.
There are some protozoa which can be parasitic, which means they feed off of different crops, animals, and even people. These protozoa may trigger illnesses in people. For instance, the protozoa plasmodium is answerable for inflicting malaria.
Another significantly harmful protozoan illnesses embrace the notorious “brain-eating amoeba” Naeglaria fowleri and the extremely severe Balamuthia mandrillaris, which carries a case-fatality fee of over 90%.
GIDEON at present catalogs data on 21 protozoan illnesses.
Algae:
Algae are available a wide range of completely different buildings. It may be single-celled, linked collectively in lengthy chains, or made up of many cells. A majority of algae varieties stay in recent or seawater and both float freely or are connected to the underside.
Many algae may develop on soil or rocks if there may be sufficient moisture current. As a result of algae include chlorophyll, they’re able to create their very own meals utilizing the method of photosynthesis.
Human consumption of seafood affected by dangerous algal blooms can doubtlessly trigger diseases equivalent to Neurotoxic Shellfish Poisoning (NSP), Ciguatera Fish Poisoning (CFP), and Diarrhetic Shellfish Poisoning (DSP).
Algae which can be members of the genus Prototheca are significantly dangerous to people, Prototheca blaschkeae being significantly harmful. Protothecosis could cause diarrhea, weight reduction, weak point, irritation of the attention (uveitis), retinal detachment, ataxia, and seizures. Chlorellosis is an identical situation brought on by an an infection of Chlorella, a kind of micro-algae that comprises excessive quantities of chloroplasts.
GIDEON at present catalogs 5 species of Prototheca, full with descriptions and the place they’re sometimes discovered.